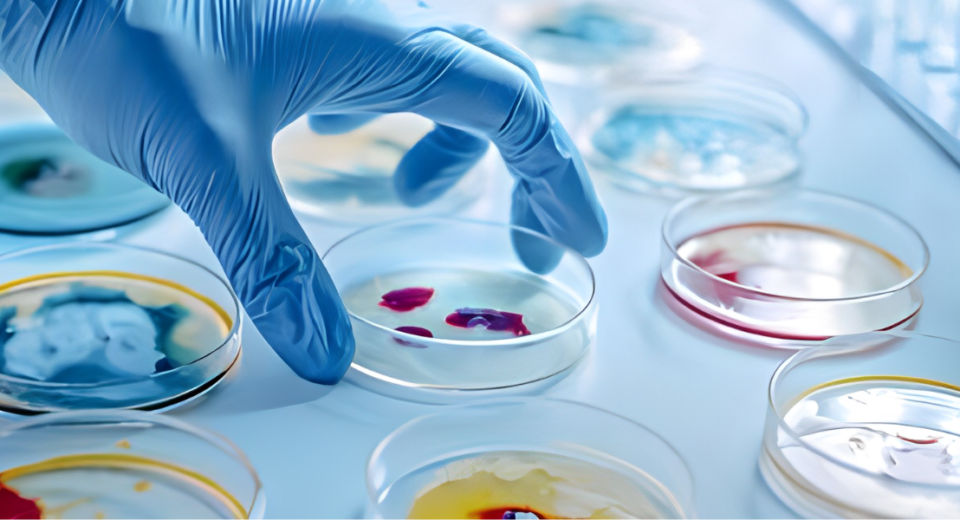

why a culture test should be done before taking antibiotic therapy
Many times, it happens that an antibiotic drug does not produce expected results or its effects differ upon different people, it may happen because there may be a variety of strength among germs. Some germs get evolved in such a way that existing drugs get useless upon them. While more important fact is that unnecessary […]